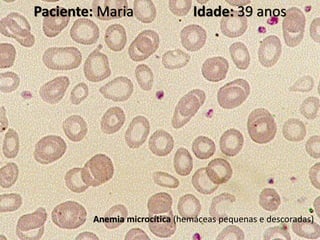
Paciente: Maria Idade: 39 anos
Anemia microcítica (hemáceas pequenas e descoradas)

O documento discute a análise de células sanguíneas por meio de um hemograma, detalhando as séries celulares e as funções dos leucócitos. Também é apresentado o caso de uma paciente chamada Maria, que foi solicitada a realizar um hemograma e outros exames, revelando anemia microcítica. Os valores laboratoriais e suas referências são especificados para análise clínica.